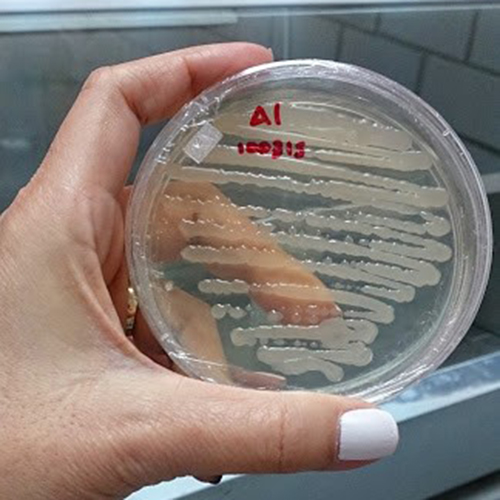

Área de Bacteriología
Un diagnóstico oportuno de bacterias fitopatógenas nos ayuda a tomar decisiones adecuadas para el manejo de enfermedades causadas por éstas. En el laboratorio de Agrodiagnóstico Fitolab, estamos comprometidos en brindar un servicio de calidad realizando diagnósticos oportunos que ayuden al productor a realizar un manejo adecuado y así evitar pérdidas económicas.